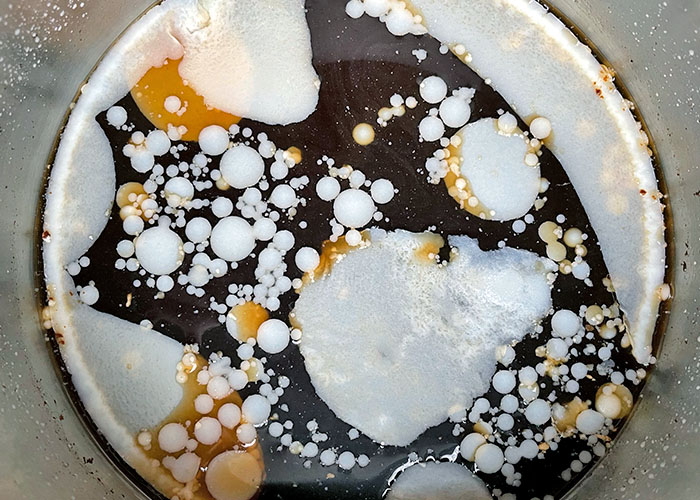
Kalte Brühe entfetten

Ein Leben ohne Schweinefleisch – das höre ich seit einiger Zeit immer öfter. Ernsthaft? Ob luftgetrocknet, geräuchert, geschmort oder gegrillt – Schweinefleisch bereichert in jeder Form unsere Teller und unzählige Länderküchen. Mein heutiges Rezept „Glasierter Schweinebauch mit Brokkolini“ ist asiatisch inspiriert und stammt ursprünglich aus China. Natürlich gibt es durchaus gute Gründe öfter mal auf Fleisch zu verzichten, einen Gemüsetag oder einen vegetarischen Monat einzulegen. Aber ein Leben ohne Parmaschinken, Lardo, Iberico, Krustenbraten oder Spareribs wäre zwar möglich aber irgendwie auch sinnlos.
Auch im Fernen Osten wird die hohe Kunst der Schweinefleischzubereitung gepflegt. Der süßliche, glasierte Schweinebauch bringt zusammen mit den Gewürzen einen Geschmack hervor, der auf der ganzen Welt geliebt wird.


Das Gericht ist eine Adaption des „Hong Shao Rou“, ein klassisches rotgeschmortes Schweinefleischgericht aus Festlandchina, das es sogar nach Wikipedia geschafft hat.
Bei meinem Rezept habe ich mich nicht zu 100% ans Original gehalten, sondern die Zubereitungsreihenfolge geändert, da sich die Zwischensteps besser zur Weiterverarbeitung eignen und das eigentliche Gericht dann in wenigen Minuten zubereitet ist.
In den chinesischen Originalen wird der Schweinebauch kurz blanchiert oder direkt angebraten, um danach lange im Soja-Zucker-Gewürze-Sud zu schmoren, bis die süßliche Soße fast ganz einreduziert ist. Bei dieser Zubereitungsart müsst ihr den Wok permanent im Auge behalten, weil durch den Zucker alles schnell verbrennen kann. Meine Version ist eine Art „Instant Variante“, die vorbereitet werden kann. Ich habe das Fleisch zunächst in aromatisierter Brühe weich gesimmert. Das hat den Vorteil, dass ich die Brühe danach als Suppenbasis für Nudelsuppen verwenden kann, und ich sie nicht bewachen muss. Der gekochte Schweinebauch kann gut eingefroren werden. Man stellt das Gericht dann fertig, wenn man Lust darauf hat. Natürlich hält sich gegartes Fleisch im Kühlschrank auch deutlich länger als rohes Fleisch.
Damit das Gericht nicht zu klebrig wird, habe ich knackiges Kohlgemüse dazu serviert. Vier heimische Trend-Kohlsorten eignen sich: Der milde knackige Jaroma Urkohl, Pak Choy, schwarzer Palmkohl und das neue Brokkolini Trend-Gemüse.
Wer direkten Kurs auf das Rezept nehmen will, kommt wie immer hier – mit einem Print-PDF – zum Ziel. Wer mehr über das Rezept und die Schweine erfahren will, bleibt bis zum Schluss hier an Bord.


Die Zutaten für zwei Personen:
Für die Brühe:
- 500 g Schweinebauch (ca. 3-4 Scheiben)
- 800 ml Hühnerbrühe Instant oder nur Wasser
- 1 daumendickes Stück Ingwer
- 1 EL dunkle Sojasauce (alt. helle Sojasauce)
- 2 Knoblauchzehen
- Schwarze Pfefferkörner
- 1 EL Zucker
- 1 Sternanis
- 1 Stück Zitronengras (optional)
Für die Glasur:
- Schwarzer oder weißer Pfeffer
- Stück Ingwer
- 1 milde rote Chili (oder Chili-Flakes)
- 1 Knoblauchzehe
- 2 EL dunkle Sojasauce (alt. helle Sojasauce & extra Zucker)
- 1 EL Honig (optional oder einfach mehr Zucker)
- 1,5 EL Zucker (braun oder weiß)
- 2-3 Frühlingszwiebeln
Beilagen:
- Grünes Wokgemüse wie Pak Choy, Brokollini, Palm- oder Jaroma-Kohl
- Reis oder Mie-Nudeln
Anmerkung: Durch die Zubereitung in drei Steps entwickelt der Schweinebauch einen raffinierten Geschmack. In der Brühe simmert der Schweinebauch langsam und bekommt schon das typische Aroma von Sternanis, Ingwer und Knoblauch. Beim Braten – dem zweiten Step – werden die mundgerechten Fleischstückchen knusprig und verlieren viel Fett. Im dritten und letzten Step glasieren sie bei niedriger Hitze für wenige Minuten in der Honig-Sojasauce.


Die Zubereitung im Detail:
Wasser oder Instant Brühe aufsetzen. Ingwer und Knoblauch fein hacken, optionales Zitronengras weichklopfen und in größere Stücke schneiden. Alles mit den restlichen Gewürzen zur Brühe geben. Die Schweinebauchscheiben in die Brühe legen. Mit Deckel zudecken und ein bis zwei Stunden leise simmern lassen. Der Schweinebauch verliert dabei schon einiges an Fett. Danach Fleisch herausnehmen und tropfentupfen. Die Brühe aufheben oder einfrieren.




Für die Glasur den gemahlenen Pfeffer, fein gehackten Ingwer, Honig und/oder Zucker, fein gehackten Knoblauch und gehackte rote Chili mit der Sojasauce anrühren. Glasur bereithalten.
Wer Reis verwendet, kann ihn jetzt nach Packungsanleitung aufsetzen.
Das Schwein in 1,5 cm dicke Streifen schneiden, falls notwendig restliche Knorpel noch herausschneiden und die Fleischstreifen bei mittlerer Hitze in der Pfanne ohne zusätzliches Fett knusprig ausbraten. Warnung: Während das Schwein brät, kann es spritzen oder sogar aus der Pfanne springen. Wer hat, kann einen Spritzschutz darüber legen. Nach etwa zehn Minuten ist das Fleisch knusprig, Kalorienzähler gießen noch etwas Fett ab. Jetzt nur noch die Soße hinzufügen und alles für wenige Minuten bei niedriger Hitze glasieren. Ab und zu schwenken oder umrühren. (Falls die Glasur zu trocken wird, noch 1-2 EL Wasser unterrühren.)
Wer Mie-Nudeln verwendet, sollte sie jetzt aufsetzen. Mie-Nudeln brauchen nur wenige Minuten. Gegarte Nudeln abgießen und auf Schalen verteilen. Alternativ die Schalen mit dem gekochtem Reis füllen. Frühlingszwiebeln und Chili kleinschneiden.
Den Schweinebauch mit Frühlingszwiebelgrün und frischen Chilis dekorieren und auf Reis oder Nudeln und mit dem grünen Gemüse servieren.

Tipp: Wer möchte, kann die gekochten Nudeln auch mit der heißen Schweinebrühe auffüllen und dekoriert den Schweinebauch und frisches Blattgemüse oben als Suppen-Topping dazu. Die aromatische Nudelsuppe ist eine besonders herzhafte Variante.


Beilage: Grünes Wokgemüse
Verschiedene Kohlgemüse wie z.B. Brokkolini bei hoher Hitze mit Knoblauch, Chili und Austernsauce im Wok für wenige Minuten scharf anbraten. Wie das genau abgeschmeckt wird, lest ihr im Pad Pad Bung Rezept hier. Das Gemüse sollte knackig und grün bleiben.

Woher kommt die Zurückhaltung beim Schweinefleisch?
Bei den großen Weltreligionen, dem Judentum und im Islam gilt das Schwein seit langem als unrein, der Verzehr ist strengstens verboten. Und auch bei uns verzichten immer mehr auf das vielseitige Fleisch. Die Gründe sind können gesundheitlicher, religiöser, moralischer und ökologischer Natur sein. Dass Schweine als Überträger von Krankheiten galten, ist nur ein Teil der Wahrheit.
Zwar gibt es Krankheiten wie die Trichinellose, die vom Schwein ausgelöst werden können. Diese Krankheit ist heute extrem selten geworden. Durch Kontrollen und Fleischbeschau ist es nahezu ausgeschlossen, sich damit zu infizieren. Auch die Schweinebandwürmer sind in Europa praktisch eliminiert worden. In ärmeren Ländern sollte man jedoch aufpassen, Ursache ist meist schlecht gelagertes Fleisch, es sollte dort unbedingt durchgebraten sein.
Dass Schweine als „dreckige“ Tiere galten, hat historisch betrachtet eher etwas mit den schlechteren Lebensbedingungen zu tun, die die domestizierten Schweine im Laufe der Zeit vorfanden. Schon seit der Jungsteinzeit gelang es den Menschen, das Wildschwein zu domestizieren und seit rund 9000 Jahren wird es überall auf der Welt für die Fleischerzeugung gehalten. Die freilaufenden Herden lebten zunächst in den Wäldern oder auf eingezäunten Weideflächen in der Nähe von Siedlungen. Dort ernährten sie sich natürlich von Eicheln, Bucheckern, Kastanien, Wurzeln, Beeren und Pilzen aber auch von Larven, Käfern oder Würmern. Sie mussten nicht gefüttert werden und waren in einem intakten Ökosystem auch keine Nahrungskonkurrenten für den Menschen. Schweine wurden in Ägypten, im gesamten Orient, der Türkei, im Iran und Irak gehalten. Eigentlich unvorstellbar heute.
Durch die Intensivierung von Ackerbau und die Abholzung der Wälder wurde das Klima trockener, es brachen ungemütlichere Zeiten für die Schweine an. Sie fanden weniger natürliche Nahrung, die Herden mussten gefüttert werden und wurden dadurch zu Nahrungskonkurrenten. In Ländern, in denen die Äcker nur noch karge Ernten hervorbrachten, wurden die Schweine zum Risiko, weil sie die Felder bei der Nahrungssuche verwüsten konnten. Schweinehaltung wurde unpopulärer, weil die Tiere im Gegensatz zu Schaf, Ziege und Rind nur zur Fleischerzeugung dienten. Schweine kann man nicht melken, während ihre Konkurrenten als Milch- und Wolllieferanten oder als Zugtiere auch im lebenden Zustand von großem Nutzen waren. Grasende Wiederkäuer fressen den Menschen nichts weg, weil Gras für uns Menschen unverdaulich ist.
Dass die Hausschweine bald als unreine Tiere galten, lag auch daran, dass sie sich in schattenlosen Gegenden im Dreck wälzen mussten, um ihre rosa Haut mit einer Schlammkruste vor Hitze und Sonnenbrand zu schützen. Schweine schwitzen nicht, sie haben keine Schweißdrüsen, deshalb bevorzugen sie schattige Wälder und kühlere Temperaturen. Je mehr ihr natürlicher Lebensraum verschwand und je ungünstiger die Bedingungen auch für die Menschen wurden, desto anfälliger wurden Schweine für Krankheiten. Die Allesfresser wurden mit Abfällen, Aas und Schlimmerem gefüttert. Was bei schlechter Haltung herauskommt, sieht man heute auch noch, wenn wieder mal ein Lebensmittelskandal ans Licht kommt. Das Füttern mit Lebensmittelabfällen ist heute aus hygienischen Gründen strengstens verboten, da Fleisch als Ursache für die Übertragung von Tierseuchen (Zoonosen) wie die Maul- und Klauenseuche, Schweinepest oder die Schweinegrippe gilt.
Der Verzicht oder die Abneigung gegen Schweinefleisch ist also eine Melange aus vielerlei Motiven. Religiöse Gründe können eine Rolle spielen, im Judentum soll seit dem 8. Jh. vor Christus das Verbot als Identitätsmerkmal und Unterscheidung zu Nicht-Juden gedient haben. Das Verbot übernahmen später auch die Muslime. Schweinefleischverbote findet man auch in der Bibel und im Hinduismus. Die Christen nahmen es mit den Verboten nicht ganz so genau, ich vermute, die Ursache liegt hier wieder bei günstigeren ökologischen Gegebenheiten. Im kühleren, bewaldeten Nord- und Mitteleuropa blieb man den Schweinen treu. Die Redewendung „Schwein haben“ kam nicht von ungefähr, das Schwein gilt hierzulande immer noch als Glücksbringer.


Dass Schwein gemieden wird, ist also eher moralisch und kulturell zu begründen. Vielleicht sind die intelligenten Schweine mit ihrer rosa Haut, ihren Schweinenasen und Ernährungsweisen den Menschen auch zu ähnlich? Wir essen in Europa auch keine Hunde und Katzen, während sie woanders als Delikatesse gelten. Alles in allem sind die Schweine zu Unrecht verpönt, denn heute spricht bei artgerechter Haltung und Kontrolle nichts mehr gegen den Genuss. Die religiösen Verbote bleiben, weil der göttliche Wille nunmal unumstößlich und nicht uminterpretierbar ist. Einen ähnlichen, fast religiösen Fanatismus sieht man heute bei den Grabenkämpfen zwischen Veganern und Fleischessern. Und weil es der guten Sache dient, versuchen manche Ideologen sogar, uns Insekten schmackhaft zu machen. Nein danke, da bleibe ich lieber beim Schwein, vor allem wenn es aus artgerechter Bio-Haltung stammt.
Heute ist China mit weitem Abstand der größte Schweineproduzent, Schweinefleisch ist in China die beliebteste Fleischart. Fast eine halbe Milliarde Hausschweine werden in Schweine gehalten, das sind mehr als 40% des weltweiten Bestands. Mittlerweile gibt es in China schon riesige Hochhäuser für die industrielle Schweineproduktion, künstliche Intelligenz steuert die Anlagen, alles ist auf maximalen Ertrag ausgerichtet. Schön ist das für die Schweine nicht, wahrscheinlich ist es nur noch eine Frage der Zeit, bis das Fleisch aus chinesischer Massentierhaltung bei uns auf den Markt drängt. Hingegen sind die europäischen Fleischexporte nach China wegen der Schweinepest und dem Importstop drastisch zurückgegangen.
Außer in Spanien nimmt der Schweinefleischbestand überall in Europa ab. Mein Bauchgefühl hat mich nicht getäuscht. Veränderte Ernährungsgewohnheiten, Inflation und gestiegene Produktionskosten sind die Gründe.

Achtet beim Einkauf deshalb auf möglichst regionale Erzeuger, Bio-Qualität oder zumindest Haltungsklasse 3 oder 4. Schweine aus Haltung in Klasse 4 müssen demnach immer die Möglichkeit zum Auslauf im Freien haben, sie erhalten Futter ohne Gentechnik und haben im Stall deutlich mehr Platz pro Tier, Stroh muss ständig verfügbar sein. Stroh dient als Beschäftigungsmaterial, was der natürlichen Lebensweise der Schweine, dem Wühlen nach Futter, am ehesten entspricht. Manchmal wird dieses Schwein auch als Strohschwein angeboten, was der Haltungsklasse 3 entspricht. Edeka bietet dieses Fleisch neben den Bio-Produkten an und hat andere Haltungsformen nicht mehr im Angebot.

Und zum Schluß noch etwas unnützes Wissen: Dänemark – unser Heimatrevier – ist das einzige Land der Welt, in dem mehr Hausschweine leben als Menschen (ca. 12 Millionen Tiere). Die meisten Schweine werden exportiert. Tipp: Die Dänen lieben ihren Schweinebauch. „Stegt flæsk“, gegrillte Schweinebauchscheiben serviert mit Petersiliensauce und Salzkartoffeln ist das Nationalgericht. Im Supermarkt gibt es rohen Schweinebauch in gigantischen Portionen und fast überall fertig gegrillten Schweinebauch in kleineren Portionen. Aus diesen gegrillten Scheiben kann das Gericht auch schnell improvisiert werden.
Und macht euch keine Sorgen, mein nächstes Rezept wird wieder vegan/vegetarisch. Die Segelsaison steht vor der Tür, bis dahin müssen noch ein paar Kilos purzeln – vor allem am Bauch. 😉

Entdecke mehr von DIE SEE KOCHT
Melde dich für ein Abonnement an, um die neuesten Beiträge per E-Mail zu erhalten.

Ich ess es inzwischen auch selten. Aber manchmal wie hier zu verführerisch
LikeGefällt 1 Person
Lieber Ole, ja bei uns wird es auch weniger. Aber ganz verzichten geht auch nicht. Dazu ist Schwein einfach zu vielseitig. Liebe Güße Cornelia
LikeGefällt 1 Person
Chapeau der Beitrag hat es in sich, wunderbar mit viel Engagement und Liebe erklärt und ein tolles Rezept. Solche Beiträge sind echte Perlen, die man nicht mehr so leicht findet!
LikeGefällt 2 Personen
Liebe Ira, danke, das ist ein tolles Kompliment. Je länger ich zu den Beiträgen recherchiere, desto mehr finde ich. Es ist so spannend zu entdecken, woher unser Essen und unsere Essgewohnheiten kommen. Und wie alles zusammenhängt. Liebe Grüße Cornelia
LikeLike
Schwein muss man haben …😉Ab und zu gerne. Wie bei allem- die Dosis macht’s. Danke für das g’schmackige Rezept 🎈
LikeGefällt 1 Person
Liebe Lore, so sieht es aus. Die Dosis macht das Gilft. Und was wäre das Leben ohne Südtiroler Speck, Parmaschinken, Schweinsbraten oder eben Schweinebauch. Liebe Grüße Cornelia
LikeGefällt 1 Person
Wie immer: fachlich sehr genau und dabei echt kurzweilig. Danke für dieses Rezept, ich habe so viele Super- Rezepte von Ihnen ausprobiert und….. wie immer Spitze! Freue mich auf die nächsten Rezepte: Egal; ob Fleisch- oder fleischlos, alles ist gut. Ahoi und Grüß,le von
Rose´
LikeGefällt 1 Person
Hallo Rose, das freut mich sehr, insbesondere wenn die Rezepte nachgekocht werden und schmecken. Liebe Grüße Cornelia
LikeLike
Einmal mehr sehr informativ – danke Cornelia!
Ohne Schwein geht hier in Thailand gar nichts. Die Vielseitigkeit spricht für sich und die verschiedenen Zubereitungsarten ebenfalls. Neben Huhn ist es das am meisten verwendete Fleisch. Und: es kommen stets alle Teile vom Schwein auf die Fleischbank, wer mag bekommt selbst einen ganzen Kopf und sämtliche Innereien (was in westlichen Ländern einfach verwurstet wird).
Mit besten Grüssen aus Fernost, Felix
LikeGefällt 1 Person
Hallo Felix, danke für die Insights. Schweineohren hatte ich mal in Portugal, die waren ziemlich knorpelig. In Thailand waren wir vermutlich in zu touristischen Gegenden unterwegs. Ausser im Glasudelsalat oder natürlich als Khao Moo Daeng und in Brühen hatte ich es nicht so auf dem Zettel. Na ja, ich habe mich auch eher an Fisch und Meeresfrüchte dort gehalten. Und viele Ziele in und um Krabi waren auch zu muslimisch geprägt. Ich schau mal auf deinem Blog. Da finden sich bestimmt einige Rezepte. Liebe Grüße Cornelia
LikeGefällt 1 Person
Liest sich sehr lecker – das wird gleich ausprobiert – Vielen Dank für deine immer wieder sehr leckeren Kochinspirationen 😁😁😁😁😁🙏🙏🙏🙏🙏
LikeGefällt 1 Person
Ciao Ossip, vielen Dank. Jetzt kommt aber bald wieder was italienisches. Versprochen.Liebe Grüße Cornelia
LikeLike
😉 Ich freu mich über jedes deiner Rezepte weil sie alle lecker sind.
LikeLike
Da haben wir aber Schwein gehabt, dass Du diesen informativen Artikel gebracht hast. Ich wollte schon länger mal diesen chin. Schweinebauch zubereiten. Das Rezept hört sich gut an. Wird nachgekocht, wenn erlaubt. Grüße aus Bonn am Rhein Hartmut
LikeGefällt 1 Person
Hallo Hartmut, das freut mich. Ich glaube, noch zarter wird es, wenn es mehrere Stunden im Sojasud schmort. Ich mag allerdings die Brühe, die so ganz nebenbei entsteht sehr. So hatte ich gestern noch eine leckere Suppe mit Pak-Choy und Nudeln. Für das Original Rezept empfehle ich dieses von Souped Up Recipes. https://www.youtube.com/watch?v=LnoauDpgivQ
Das ist ein ganz toller Kanal für gut erklärte chinesische Rezepte. Bin gespannt wie dein Rezept wird.
Liebe Grüße Cornelia
LikeLike
Danke für das Rezept aber auch für den Hinweis, dass beim Anbraten durchaus Spritzer aus der Pfanne (bei mir -Wok) kommen und das Fleisch sogar heraus springen kann. Ich dachte, ich habe alles falsch gemacht, Schweinebauch zu kurz gekocht o.ä. Grüße aus Cottbus
LikeGefällt 1 Person
Hallo Rüdiger, das hat mich auch sehr erschreckt. Ich hoffe, es hat geschmeckt und war trotz kurzer Kochzeit nicht allzu zäh. Grüße zurück aus Hamburg, Cornelia
LikeLike